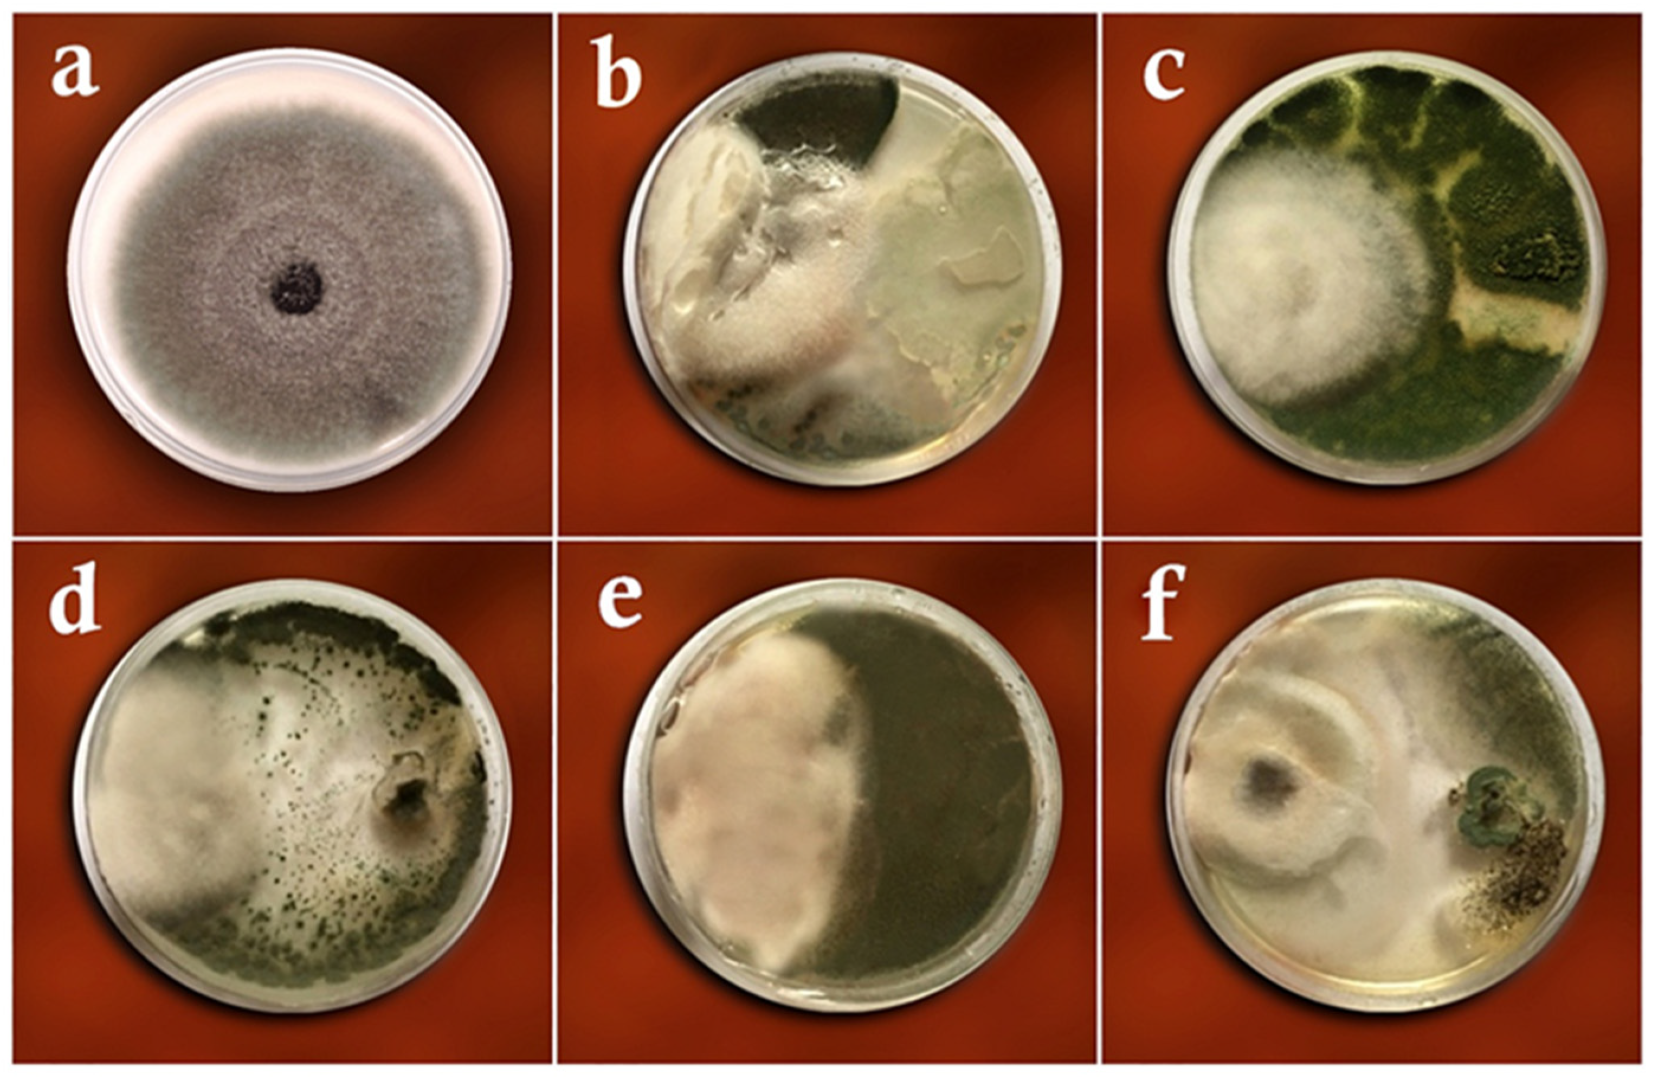
Biology 11 01282 g004
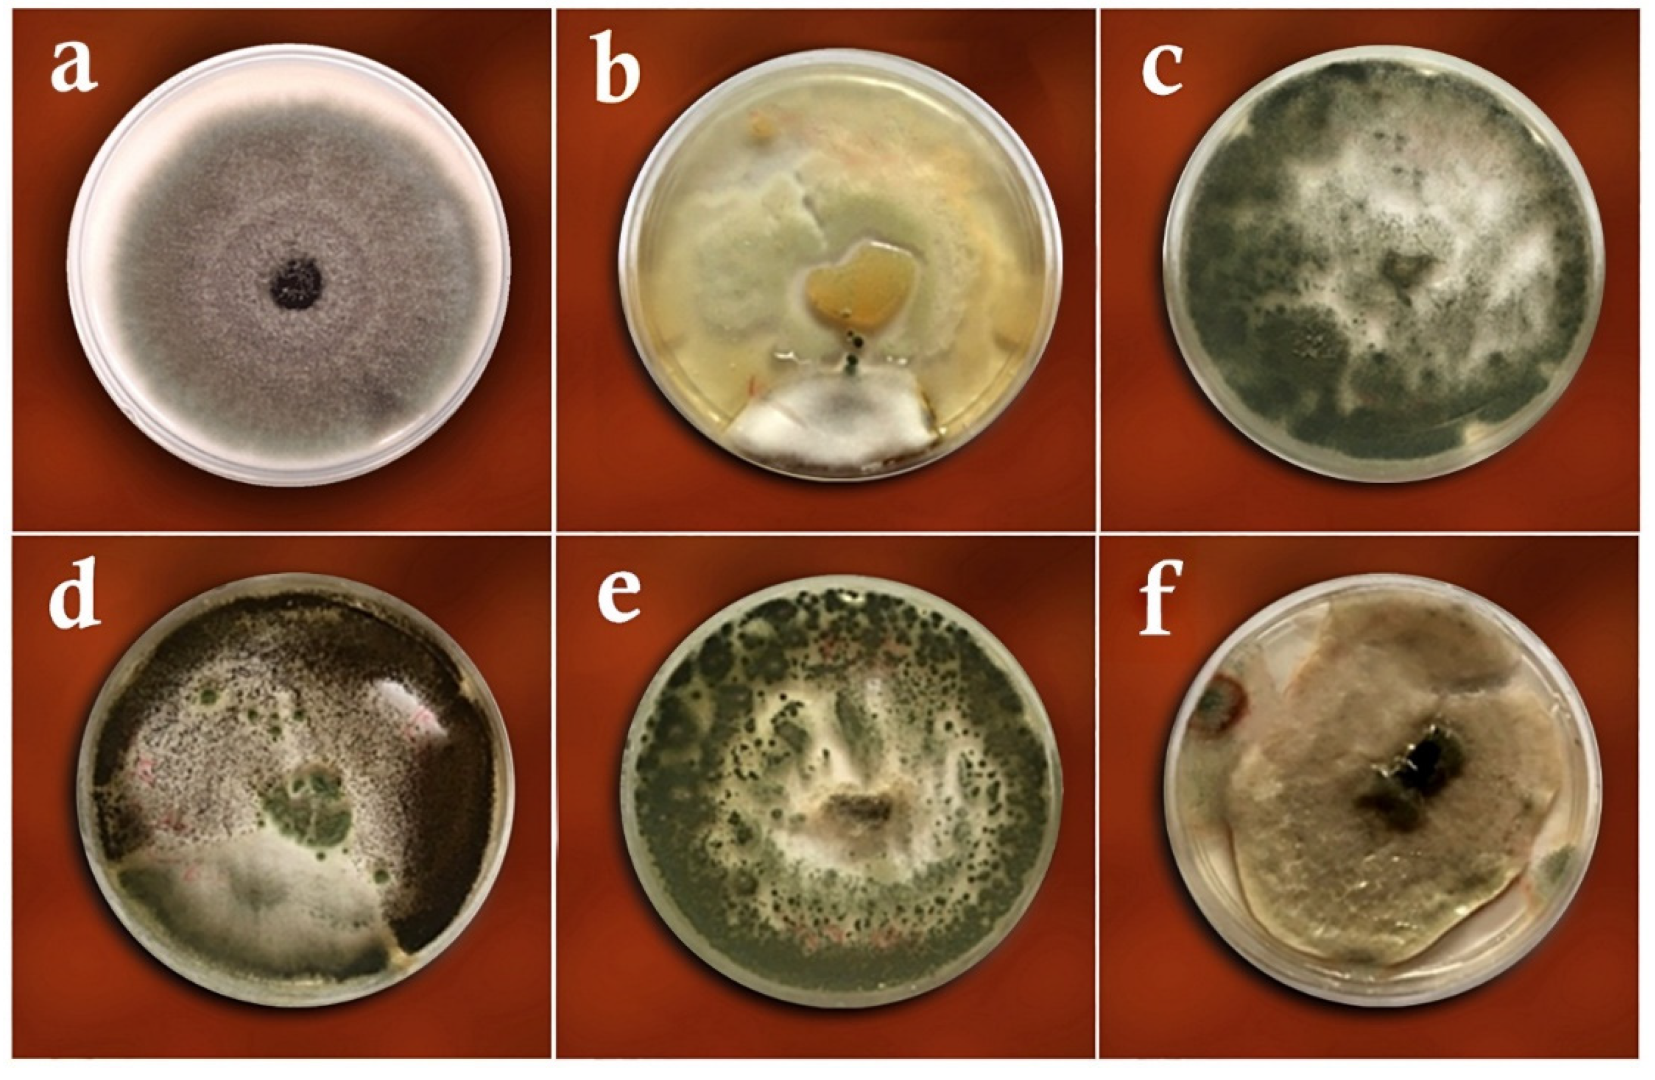
Biology 11 01282 g005

Endophytic Fungi as Potential Biocontrol Agents against Rhizoctonia solani J.G. Kühn, the Causal Agent of Rice Sheath Blight Disease
Abstract
:Simple Summary
Abstract
1. Introduction
2. Materials and Methods
2.1. Sampling and Isolation
2.2. Identification of Fungi
2.3. Biological Control Studies
2.3.1. Dual Culture Method
2.3.2. Volatile Metabolites Method
2.3.3. Slide Culture Method
2.4. Greenhouse Studies
2.5. Data Analysis
3. Results
3.1. Dual-Culture Assay
3.2. Volatile Metabolites Assay
3.3. Slide Culture Assay
3.4. Greenhouse Studies
3.4.1. Evaluation of Disease Rating
3.4.2. Evaluation of Plant Height
3.4.3. Evaluation of Plant Fresh Weight
3.4.4. Evaluation of Plant Dry Weight
4. Discussions
5. Conclusions
Author Contributions
Funding
Institutional Review Board Statement
Informed Consent Statement
Data Availability Statement
Acknowledgments
Conflicts of Interest
References
- Fu, D.; Zhong, K.; Zhong, Z.; Hu, G.; Zhang, P.; Tong, H. Genome-Wide Association Study of Sheath Blight Resistance within a Core Collection of Rice (Oryza sativa L.). Agronomy 2022, 12, 1493. [Google Scholar] [CrossRef]
- Prabhukarthikeyan, S.R.; Parameswaran, C.; Sawant, S.B.; Naveenkumar, R.; Mahanty, A.; Keerthana, U.; Yadav, M.K.; Anandan, A.; Panneerselvam, P.; Bag, M.K.; et al. Comparative proteomic analysis of Rhizoctonia solani isolates identifies the differentially expressed proteins with roles in virulence. J. Fungi 2022, 8, 370. [Google Scholar] [CrossRef] [PubMed]
- Lu, Y.; Li, Z.; Zhao, X.; Lv, S.; Wang, X.; Wang, K.; Ni, H. Recognition of rice sheath blight based on a backpropagation neural network. Electronics 2021, 10, 2907. [Google Scholar] [CrossRef]
- Chakusari, M.K.; Rostaei, A.; Padasht Dehkaee, F.; Khodakaramian, Q. Biocontrol of rice sheath blight disease caused by Rhizoctonia solani fungus using certain antagonistic bacteria in the province of Guilan. J. Plant Protec. 2012, 26, 44–54. [Google Scholar]
- Li, S.; Yan, Q.; Wang, J.; Peng, Q. Endophytic fungal and bacterial microbiota shift in rice and barnyardgrass grown under co-culture condition. Plants 2022, 11, 1592. [Google Scholar] [CrossRef]
- Atanasova, L.; Crom, S.L.; Gruber, S.; Coulpier, F.; Seidl-Seiboth, V.; Kubicek, C.P.; Druzhinina, I.S. Comparative transcriptomics reveals different strategies of Trichoderma mycoparasitism. BMC Genom 2013, 14, 121. [Google Scholar] [CrossRef]
- Cook, R.J.; Baker, K.F. The Nature and Practice of Biological Control of Plant Pathogen; The American Phytopathological Society: St. Paul, MN, USA, 1983. [Google Scholar]
- Gams, W.; Bissett, J. Morphology and identification of Trichoderma. In Trichoderma & Gliocladium. Basic Biology, Taxonomy and Genetics; Kubicek, C.P., Harman, G.E., Eds.; Taylor and Francis Ltd.: London, UK, 1998; Volume 1, pp. 3–34. [Google Scholar]
- Benitez, T.; Delgado-Jarana, J.; Rincon, A.; Key, M.; Limin, M.C. Biofungicides: Trichoderma as a biocontrol against phytopathogenic fungi. Recent Res. Devel. Microbiol. 1998, 2, 129–150. [Google Scholar]
- Dehkaee, F.P.; Okhovvat, S.M.; Javan-Nikkhah, M.; Mahmoodi, S.B. Optimization of infection method in sheath blight disease for distinguishing real reactions of rice varieties in paddies. Iran. J. Plant Protect. Sci. 2009, 40, 99–108. [Google Scholar]
- Nzojiyobiri, J.B.; Xu, T.; Song, F.; Shen, Y. Resistance induced by Trichoderma harzianum NF9 against Magnaporthe grisea and Xanthomonas oryzae pv. Oryzae in rice. Chin. J. Biologic. Control. 2003, 3, 111–114. [Google Scholar]
- Harman, G.E. Overview of mechanisms and uses of Trichoderma spp. Phytopathology 2006, 96, 190–194. [Google Scholar] [CrossRef]
- Singh, V.; Joshi, B.B. Mass multiplication of Trichoderma harzianum on sugarcane press mud. Indian Phytopathol. 2007, 60, 530–531. [Google Scholar]
- Naeimi, S.; Okhovvat, S.M.; Javan-Nikkhah, M.; Kredics, L.; Khosravi, V. Biological control of Rhizoctonia solani AG1-1A, the causal agent of rice sheath blight with Trichoderma strains. Phytopathol. Mediterr. 2010, 49, 287–300. [Google Scholar]
- Kotasthane, A.; Agrawal, T.; Kushwah, R.; Rahatkar, O.V. In-vitro antagonism of Trichoderma spp. against Sclerotium rolfsii and Rhizoctonia solani and their response towards growth of cucumber, bottle gourd and bitter gourd. Eur. J. Plant Pathol. 2015, 141, 523–543. [Google Scholar] [CrossRef]
- Anees, M.; Tronsmo, A.; Edel-Hermann, V.; Hjeljord, L.G.; Heraud, C.; Steinberg, C. Characterization of field isolates of Trichoderma antagonistic against Rhizoctonia solani. Fungal Biol. 2011, 114, 691–701. [Google Scholar] [CrossRef]
- Matloob, A.H.; Juber, K.S. Biological control of bean root rot disease caused by Rhizoctonia solani under green house and field conditions. Agric. Biol. J. N. Am. 2013, 4, 512–519. [Google Scholar] [CrossRef]
- Khodaee, M.; Hemati, R. The efficacy of Trichoderma isolates in biocontrol of Rhizoctonia root rot of beans in Zanjan province. J. Plant Protec. 2015, 29, 471–480. [Google Scholar]
- Shrestha, B.K.; Karki, H.S.; Groth, D.E.; Jungkhun, N.; Ham, J.H. Biological control activities of rice-associated Bacillus sp. strains against sheath blight and bacterial panicle blight of rice. PLoS ONE 2016, 11, e0146764. [Google Scholar] [CrossRef] [Green Version]
- Nicolaisen, M.H.; Cuong, N.D.; Herschend, J.; Jensen, B.; Loan, L.C.; Van Du, P.; Sørensen, J.; Sørensen, H.; Olsson, S. Biological control of rice sheath blight using hyphae-associated bacteria: Development of an in planta screening assay to predict biological control agent performance under field conditions. BioControl 2018, 63, 843–853. [Google Scholar] [CrossRef]
- Jamali, H.; Sharma, A.; Roohi; Srivastava, A.K. Biocontrol potential of Bacillus subtilis RH5 against sheath blight of rice caused by Rhizoctonia solani. J. Basic Microbiol. 2020, 60, 268–280. [Google Scholar] [CrossRef]
- Alam, B.; Lǐ, J.; Gě, Q.; Khan, M.A.; Gōng, J.; Mehmood, S.; Yuán, Y.; Gǒng, W. Endophytic fungi: From symbiosis to secondary metabolite communications or vice versa? Front. Plant Sci. 2021, 12, 791033. [Google Scholar] [CrossRef]
- Safari Motlagh, M.R. Isolation and characterization of some important fungi from Echinochloa spp. the potential agents to control rice weeds. Aust. J. Crop. Sci. 2010, 4, 457–460. [Google Scholar]
- Ellis, M.B. Dematiaceous Hyphomycetes; CMI: London, UK, 1971. [Google Scholar]
- Sivanesan, A. Gramainicolous Species of Bipolaris, Curvularia, Drechslera, Exserohilum and Their Teleomorphs; CAB International Mycological Institute: Wallingford, UK, 1987. [Google Scholar]
- Reper, K.B.; Fennell, D.I. The Genus Aspergillus; William & Wilkins Co.: Baltimore, MD, USA, 1965. [Google Scholar]
- Samson, R.A.; Hong, S.; Peterson, S.W.; Frisvad, J.C.; Varga, J. Polyphasic taxonomy of Aspergillus section Fumigati and its teleomorph. Neosartorya Stud. Mycol. 2007, 59, 147–203. [Google Scholar] [CrossRef]
- Shah, M.M.; Afiya, H. Introductory Chapter: Identification and Isolation of Trichoderma spp.-Their Significance in Agriculture, Human Health, Industrial and Environmental Application. In Trichoderma-The Most Widely Used Fungicide; Shah, M.M., Sharif, U., Buhari, T.R., Eds.; IntechOpen Limited: London, UK, 2019. [Google Scholar] [CrossRef]
- White, T.J.; Bruns, T.; Lee, S.; Taylor, J.V. Amplification and direct sequencing of fungal ribosomal RNA genes for phylogenetics. In PCR Protocols: A Guide to Methods and Applications; Innis, M.A., Gelfand, D.H., Sninsky, J.J., White, T.J., Eds.; Academic Press: New York, NY, USA, 1990; pp. 315–322. [Google Scholar]
- Koressaar, T.; Lepamets, M.; Kaplinski, L.; Raime, K.; Andreson, R.; Remm, M. Primer3_masker: Integrating masking of template sequence with primer design software. Bioinformatics 2018, 34, 1937–1938. [Google Scholar] [CrossRef]
- The National Center for Biotechnology Information. Available online: http://www.ncbi.nlm.nih.gov/ (accessed on 16 August 2022).
- Sivakumar, D.; Wilson Wijeratnam, R.S.; Wijesundera, R.L.C.; Marikar, F.M.T.; Abeyesekere, M. Antagonistic effect of Trichoderma harzianum on postharvest pathogens of Rambutan (Nephelium lappaceum). Phytoparasitica 2000, 28, 240–247. [Google Scholar] [CrossRef]
- Motlagh, M.R.S.; Dehkaee, F.P.; Hedjaroud, G.A. Rice brown spot disease and evaluation of the response of some rice cultivars to it. J. Sci. Technol. Agric. Nat. Res. 2005, 9, 171–182. [Google Scholar]
- Horsfall, J.G.; Barratt, R.W. An improved grading system for measuring plant diseases. Phytopathology 1945, 35, 655. [Google Scholar]
- Bertrand, P.F.; Gottwald, T.R. Evaluation of fungicides for pecan disease control. In Methods for Evaluating Pesticides for Control of Plant Pathogens; Hickey, K.D., Ed.; Oxford and IHB Publisher: Calcatte, India, 1997; pp. 179–181. [Google Scholar]
- Ibrahim, M.; Oyebanji, E.; Fowora, M.; Aiyeolemi, A.; Orabuchi, C.; Akinnawo, B.; Adekunle, A.A. Extracts of endophytic fungi from leaves of selected Nigerian ethnomedicinal plants exhibited antioxidant activity. BMC Complement Med. Ther. 2021, 34, 98. [Google Scholar] [CrossRef]
- Abbas, A.; Jiang, D.; Fu, Y. Trichoderma spp. as antagonist of Rhizoctonia solani. J. Plant Pathol. Microbiol. 2017, 8, 402–411. [Google Scholar] [CrossRef]
- Hanson, L.E. Reduction of Verticillium wilt symptoms in cotton following seed treatment with Trichoderma virens. J. Cotton Sci. 2004, 4, 224–231. [Google Scholar]
- Guo, Y.; Jud, W.; Weikl, F.; Ghirardo, A.A.; Junker, R.R.; Polle, A.; Benz, J.P.; Pritsch, K.; Schnitzler, J.P.; Rosencrantz, M. Volatile organic compound patterns predict fungal trophic mode and lifestyle. Commun. Biol. 2021, 4, 673. [Google Scholar] [CrossRef]
- Safari Motlagh, M.R. Biological control of Bipolaris victoriae, the causal agent of brown spot disease of rice by Alternaria spp. in Guilan province. Plant Prot. J. 2017, 40, 41–60. [Google Scholar] [CrossRef]
- Javadi, L.; Naeimi, S.; Rezaee, S.; Khosravi, V. Biological control of rice blast disease with native Trichoderma isolates in Mazandaran province, Iran. Biocontrol Plant Protect. 2014, 2, 1–15. [Google Scholar]
- Singh, V.; Sing, U.S.; Sing, K.P.; Kumar, A. Genetic diversity of Rhizoctonia solani isolates from rice: Differentiation by morphological characteristics, pathogenicity, anastomosis behavior and RAPD fingerprinting. J. Mycol. Plant Pathol. 2004, 32, 332–344. [Google Scholar]
- Harman, G.E.; Howell, C.R.; Viterbo, A.; Chet, I.; Lorito, M. Trichoderma species-opportunistic, avirulent plant symbionts. Nat. Rev. Microbiol. 2004, 2, 43–56. [Google Scholar] [CrossRef]
- Verma, M.; Brar, S.K.; Tyagi, R.D.; Surampalli, R.Y.; Valero, J.R. Antagonistic fungi, Trichoderma spp. panoply of biological control. Biochem. Eng. J. 2007, 37, 1–20. [Google Scholar] [CrossRef]
- Ghisalberti, E.L.; Narbey, M.J.; Dewan, M.M.; Sivaithamparam, K. Variability among strains of Trichoderma harzianum in the inability to reduce take-all and to produce pyrons. Plant Soil 1990, 121, 287–291. [Google Scholar] [CrossRef]
- Papavizas, G.C. Trichoderma and Gliocladium biology, ecology and the potential for biocontrol. Annu. Rev. Phytopathol. 1985, 23, 23–54. [Google Scholar] [CrossRef]
- Akrami, M.; Golzary, H.; Ahmadzadeh, M. Evaluation of different combinations of Trichoderma species for controlling Fusarium rot of lentil. Afr. J. Biotechnol. 2011, 10, 2653–2658. [Google Scholar] [CrossRef]
- Toda, T.; Hyakumachi, M.; Arora, D.K. Genetic relatedness among and within different isolates of Rhizoctonia solani anastomosis groups as assessed by RAPD, ERIC and REP-PCR. Microbiol. Res. 1999, 154, 247–258. [Google Scholar] [CrossRef]
- Bandyopadhyay, R.; Cardwell, K.F. Species of Trichoderma and Aspergillus as biological control agents against plant diseases in Africa. In Biological Control in IPM Systems in Africa; Neuenschwander, P., Borgemeister, C., Langewald, J., Eds.; CAB International: Wallingford, UK, 2003; pp. 193–206. [Google Scholar]
- Rosada, L.J.; Sant’anna, J.R.; Franco, C.C.; Esquissato, G.N.; Santos, P.A.; Yajima, J.P.; Ferreira, F.D.; Machinski, M.; Corrêa, B.; Castro-Prado, M.A. Identification of Aspergillus flavus isolates as potential biocontrol agents of aflatoxin contamination in crops. J. Food Protect. 2013, 76, 1051–1055. [Google Scholar] [CrossRef]
- Aybeke, M.; Sen, B.; Okten, S. Aspergillus alliaceus, a new potential biological control of the root parasitic weed Orobanche. J. Basic Microbiol. 2014, 4, 93–101. [Google Scholar] [CrossRef]
- Nguyen, P.T.; Wacker, T.; Brown, A.J.P.; da Silva Dantas, A.; Shekhova, E. Understanding the role of nitronate monooxygenases in virulence of the human fungal pathogen Aspergillus fumigatus. J. Fungi 2022, 8, 736. [Google Scholar] [CrossRef]

| Name | Sequence (5′→3′) | TM | GC% | Mer |
|---|---|---|---|---|
| 18s rDNA-F | CACCAGACTTGCCCTCCA | 58.24 | 61.1 | 18 |
| 18s rDNA-R | AACCTGGTTGATCCTGCCAG | 59.35 | 55 | 20 |
| Fungal Isolates | Colonial Growth in the Treatments (mm) | Colonial Growth in the Control (mm) | Growth Inhibition (%) | Colonial Growth in the Treatments (mm) | Colonial Growth in the Control (mm) | Growth Inhibition (%) |
|---|---|---|---|---|---|---|
| Dual Culture | Volatile Metabolites | |||||
| Aspergillus awamori | 48.66 ± 0.21 a | 78.00 ± 0.00 a | 37.61 ± 0.01 a | 42.00 ± 0.01 a | 78.00 ± 0.00 a | 46.00 ± 0.01 b |
| Aspergillus fumigatus | 44.66 ± 0.02 a | 78.00 ± 0.00 a | 42.74 ± 0.01 a | 25.00 ± 0.01 c | 80.00 ± 0.01 a | 68.75 ± 0.01 a |
| Curvularia lunata | 46.00 ± 0.03 a | 78.00 ± 0.00 a | 41.02 ± 0.01 a | 48.00 ± 0.01 a | 78.00 ± 0.01 a | 38.46 ± 0.01 c |
| Trichoderma harzianum | 47.00 ± 0.01 a | 78.00 ± 0.00 a | 39.74 ± 0.01 a | 43.00 ± 0.01 a | 75.00 ± 0.01 a | 42.66 ± 0.21 b |
| Trichoderma virens | 43.55 ± 0.01 a | 78.00 ± 0.00 a | 44.16 ± 0.02 a | 30.00 ± 0.01 b | 80.00 ± 0.01 a | 62.50 ± 0.01 a |
| Treatment | Disease Rating Index | Reduction in Disease Rating (%) | Plant Traits | ||
|---|---|---|---|---|---|
| Height (cm) | Fresh Weight (g) | Dry Weight (g) | |||
| Negative control | - | - | 55.00 ± 0.02 a | 12.00 ± 0.02 a | 2.00 ± 0.02 a |
| Positive control | 10.00 ± 0.00 a | 0.00 ± 0.00 d | 30.00 ± 0.03 d | 7.30 ± 0.03 c | 0.35 ± 0.03 c |
| Aspergillus awamori | 6.97 ± 0.00 b | 30.3 ± 0.03 c | 38.00 ± 0.02 c | 7.40 ± 0.03 c | 0.73 ± 0.00 b |
| Aspergillus fumigatus | 6.33 ± 0.00 b | 36.7 ± 0.04 ab | 47.66 ± 0.14 b | 10.00 ± 0.06 b | 0.96 ± 0.05 b |
| Curvularia lunata | 7.30 ± 0.00 b | 27.0 ± 0.04 cd | 37.33 ± 0.13 c | 5.90 ± 0.12 d | 0.61 ± 0.00 b |
| Trichoderma harzianum | 6.89 ± 0.00 b | 31.1 ± 0.06 c | 47.00 ± 0.00 b | 9.16 ± 0.00 bc | 0.92 ± 0.00 b |
| Trichoderma virens | 5.86 ± 0.00 b | 41.4 ± 0.05 a | 50.66 ± 0.02 b | 10.00 ± 0.02 b | 1.01 ± 0.03 b |
Publisher’s Note: MDPI stays neutral with regard to jurisdictional claims in published maps and institutional affiliations. |
© 2022 by the authors. Licensee MDPI, Basel, Switzerland. This article is an open access article distributed under the terms and conditions of the Creative Commons Attribution (CC BY) license (https://creativecommons.org/licenses/by/4.0/).
Share and Cite
Safari Motlagh, M.R.; Jahangiri, B.; Kulus, D.; Tymoszuk, A.; Kaviani, B. Endophytic Fungi as Potential Biocontrol Agents against Rhizoctonia solani J.G. Kühn, the Causal Agent of Rice Sheath Blight Disease. Biology 2022, 11, 1282. https://doi.org/10.3390/biology11091282
Safari Motlagh MR, Jahangiri B, Kulus D, Tymoszuk A, Kaviani B. Endophytic Fungi as Potential Biocontrol Agents against Rhizoctonia solani J.G. Kühn, the Causal Agent of Rice Sheath Blight Disease. Biology. 2022; 11(9):1282. https://doi.org/10.3390/biology11091282
Chicago/Turabian StyleSafari Motlagh, Mohammad Reza, Bahar Jahangiri, Dariusz Kulus, Alicja Tymoszuk, and Behzad Kaviani. 2022. "Endophytic Fungi as Potential Biocontrol Agents against Rhizoctonia solani J.G. Kühn, the Causal Agent of Rice Sheath Blight Disease" Biology 11, no. 9: 1282. https://doi.org/10.3390/biology11091282
APA StyleSafari Motlagh, M. R., Jahangiri, B., Kulus, D., Tymoszuk, A., & Kaviani, B. (2022). Endophytic Fungi as Potential Biocontrol Agents against Rhizoctonia solani J.G. Kühn, the Causal Agent of Rice Sheath Blight Disease. Biology, 11(9), 1282. https://doi.org/10.3390/biology11091282

